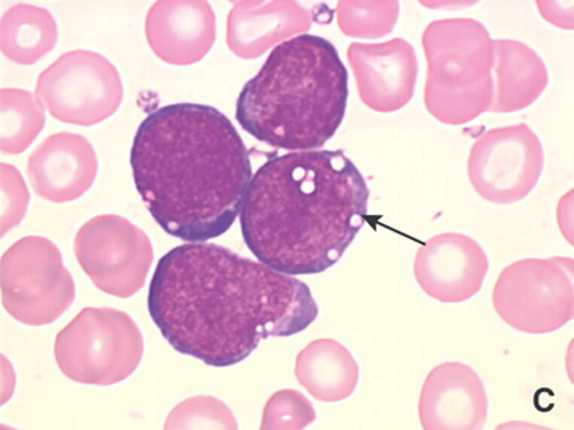

Adherencia al Tratamiento
En esta oportunidad con la sección Adherencia al tratamiento, con El Señor Cristian Neves, Psicólogo de la Fundación Arturo López Pérez, se dirige a nosotros en el módulo MaxiVida Responde.
Leer artículoApoyo informativo, médico y legal para pacientes y familiares. Juntos recorremos el camino.
Busca patologías, blogs o noticias

Mantente informado
Ofrecemos apoyo integral y educación continua en enfermedades hematológicas y oncológicas específicas.
La leucemia linfoblástica aguda (LLA) se debe a una lesión adquirida o congénita del ADN de una sola célula en la médula ósea. La LLA (que también se llama leucemia linfocítica aguda) es un cáncer de la sangre y la médula ósea. Por lo general, este tipo de cáncer empeora rápido si no se trata.

La leucemia mieloide crónica (LMC) es un tipo de cáncer no hereditario que se desarrolla en la médula ósea y, en la mayoría de los casos, ocurre en adultos en el grupo de edad de los 50 años (sólo el 4% de los pacientes son niños). Aún no se sabe con certeza el motivo de su aparición, pero los médicos afirman que es una enfermedad adquirida, que no está presente en el momento de nuestro nacimiento, y no es hereditaria.

La leucemia mieloide aguda (LMA) es un cáncer que comienza dentro de la médula ósea. Esta es el tejido blando en el interior de los huesos que ayuda a formar las células sanguíneas. El cáncer crece a partir de las células que normalmente se convertirían en glóbulos blancos. Algunas veces se propaga a otras partes del cuerpo, incluyendo los ganglios linfáticos, el hígado, el bazo, el sistema nervioso central (el cerebro y la médula espinal) y los testículos.
Nuestra red de apoyo legal y médico abarca múltiples áreas.
Recibimos tu caso y te brindamos información clara sobre tu patología y los pasos a seguir en el sistema de salud.
Información acerca de las enfermedades y los tratamientos..
Contacto con otros pacientes y familiares. Reuniones periódicas y actividades grupales.
Los miembros de la comunidad hablan
Registros de nuestra labor
+ de 500 fotos compartidas



En esta oportunidad con la sección Adherencia al tratamiento, con El Señor Cristian Neves, Psicólogo de la Fundación Arturo López Pérez, se dirige a nosotros en el módulo MaxiVida Responde.
Leer artículo
El Señor Cristian Neves, Psicólogo de la Fundación Arturo López Pérez, se dirige a nosotros en el módulo MaxiVida Responde.
Leer artículo